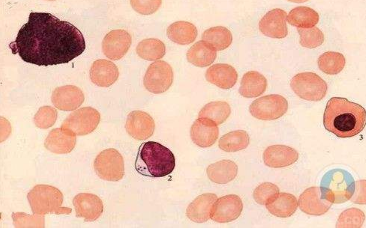

是这样的,戴不戴眼镜要跟他使用的晶体,就是他手术中间用的人工晶体相关,如果他用的是普通的晶体,您就往眼镜上想,假如说您就是一个普通的眼镜,那可能您需要配戴眼镜。
因为我们做完这个晶体以后,您本来就是花眼,或者您是个近视,那您还是花眼或者近视,如果说您想不戴眼镜,那您可能可以用一个我们现在晶体有那种叫做多焦晶体,就跟眼镜一模一样,就是它可以看远,也可以看近,咱眼镜也有这样双光镜,晶体也有双光的,有三光的。
还有一些所谓有一点点调节的,就是有一点点能像咱们人的晶体仿生一样,就仿那年轻人的晶体,但都不是很过关,都不如咱年轻时候那晶体好,只不过是说,有一点双光的效果,有这样的晶体。
但是这样的晶体也有它的问题,第一是手术要非常好,这个晶体才能用,第二年戴着这晶体您得练,我不知道您戴没戴过双光眼镜,就是您看前头的时候往前看,看下边的时候不能低头,不能跟咱原来一样,您得用下半截,所以您得把眼镜放低这样看,下楼的时候可能开始有点晕。
类似这种东西这要克服就是有好多种办法,可能让您对眼镜的依赖性会低一些,但是完全不戴眼镜,您就先别抱着这想法有可能会实现,但是不是很稳定,所以您别想到那么好您把心态放低点,结果您就满意一点。
本文地址://m.diplomatpc.com/tjcs/83051.html

深圳